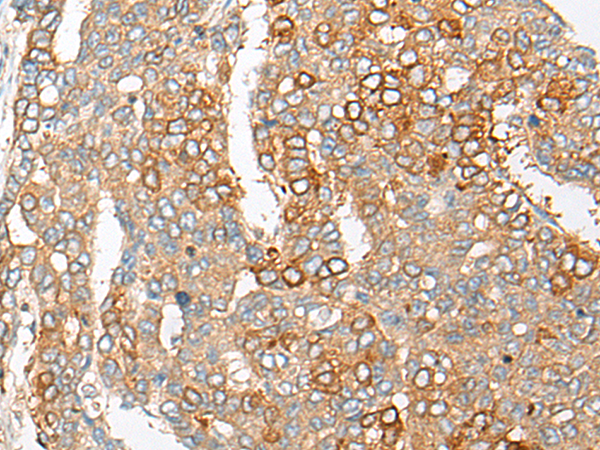

-
分类: 科研抗体货号: P13172别名: LPIR1应用: WB,IHC反应种属: Human
-
分类: 科研抗体货号: P13171别名: COX6AH; COXVIAH应用: WB,IHC反应种属: Human, Mouse, Rat
-
分类: 科研抗体货号: P13186别名: PDXPO; HEL-S-302应用: WB,IHC反应种属: Human, Mouse, Rat
-
分类: 科研抗体货号: P13170别名: RON; PTK8; CD136; CDw136应用: IHC反应种属: Human
-
分类: 科研抗体货号: P13175别名: LKLF应用: IHC反应种属: Human, Mouse, Rat
-
分类: 科研抗体货号: P13185别名: PCDH-GAMMA-B5应用: IHC反应种属: Human
-
分类: 科研抗体货号: P13168别名: CLIPINC应用: WB,IHC反应种属: Human, Mouse
-
分类: 科研抗体货号: P13174别名: DIF2; IEX1; PRG1; DIF-2; GLY96; IEX-1; IEX-1L应用: IHC反应种属: Human, Mouse
-
分类: 科研抗体货号: P13184别名: OSX; OI11; OI12; osterix应用: IHC反应种属: Human, Mouse
-
分类: 科研抗体货号: P13167别名: L1.2; LRE1应用: WB,IHC反应种属: Human

鄂公网安备42018502007531号
鄂公网安备42018502007531号

